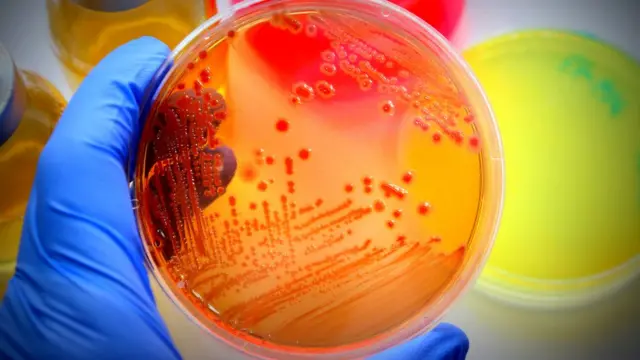
Un examen microbiológico

Por qué algunos medicamentos continúan siendo caros pese a tener la patente caducada

Fuente de la imagen, 6okean
- Autor, Stefania Gozzer
- Título del autor, BBC Mundo
Durante años, la farmacéutica Pfizer tuvo en el Lipitor su gallina de los huevos de oro.
La pastilla que reduce drásticamente los niveles de colesterol llegó a ser el medicamento más vendido en el mundo.
Las ventas alcanzaron en 2006, su año cúspide, los US$12.900 millones. En esa época, el Lipitor suponía entre el 20% y el 25% de los ingresos de la compañía.
Hasta que la patente caducó en 2011 y versiones más baratas comenzaron a aparecer.
El año pasado, Pfizer sólo facturó US$1.760 millones por la comercialización de este fármaco, un 86% menos que durante su punto álgido.
Este es sólo un ejemplo de cómo los genéricos han revolucionado el sector farmacéutico.
Cuando una empresa pierde el derecho exclusivo a fabricar un medicamento, se abre la puerta a que cualquiera desarrolle su versión de la fórmula.
Una vez que esta entra en el mercado, sólo queda esperar unosocho meses para ver cómo caen los precios, según un estudio publicado por la consultora especializada IMS Health.
Fuente de la imagen, Ca-ssis
Los pacientes pueden llegar a pagar hasta un 90% menos que el precio inicial, según los datos de esta firma.
Pero hay una clase especial de medicamentos a los que esto no se aplica.
Sus licencias han comenzado a expirar y se espera que muchas más venzan en los próximos años.
Y pese a que otros fabricantes han creado sus propias versiones, sus precios no han dejado de estar compuestos por tres o más dígitos.
Medicamentos vivos
A diferencia de los fármacos químicos, los biológicos no se producen a través de una síntesis química.
Se trata de moléculas mucho más complejas que derivan de seres vivos: proteínas como hormonas o anticuerpos.
El ser humano los produce en condiciones normales, pero esta capacidad se puede ver afectada por enfermedades como el cáncer, la diabetes, el asma o la enfermedad inflamatoria intestinal, entre otras.
A diferencia de los químicos, no toman la forma de pastillas sino que la mayoría son inyectables.
Entre los ejemplos más conocidos están la hormona del crecimiento y la insulina glargina, usada por quienes padecen de diabetes.
También los usan los pacientes que reciben quimioterapia para poder elevar sus niveles de glóbulos rojos (G-CSF)y blancos (EPO).

Fuente de la imagen, Ridofranz
Los medicamentos biológicos son cruciales para enfermedades crónicas y otras que pueden llevar a la muerte, por lo que su precio es un asunto vital para muchas familias.
Para las farmacéuticas también: estas medicinas representan una parte importante de sus ingresos.
Las ventas podrían disminuir en US$60.000 millones durante los próximos tres años por la pérdida de patentes, según un estudio del fondo de inversión Sanford C. Bernstein & Co. publicado por Bloomberg.
La farmacéutica Roche sería una de las más afectadas, según este medio.
Las licencias de tres de sus fármacos para el cáncer caducarán en los próximos dos años. Estos aportan US$20.000 millones, el 39% de sus ventas mundiales.
Los biosimilares
Pero las grandes multinacionales del sector parecen no estar muy preocupadas.
El motivo es que, a diferencia de los químicos, los medicamentos biológicos no son tan fáciles de copiar.
Crear un sustituto es difícil, pero no imposible: varias empresas llevan más de una década desarrollando versiones más económicas que reciben el nombre de biosimilares.

Fuente de la imagen, fluxfoto
Aunque los expertos advierten de que estos no tendrán el mismo efecto que los genéricos tuvieron en el mercado.
"Desarrollar un biosimilar es mucho más costoso que un genérico", explicó a BBC Mundo el director del Centro de Estudios Interdisciplinarios de Derecho Industrial y Económico de la Universidad de Buenos Aires, Carlos Correa.
Para conseguir un genérico se ha de invertir entre US$600.000 y US$4 millones de euros, mientras que un biosimilar cuesta entre US$100 millones y US$300 millones, según los datos de la Asociación Española de Biosimilares (Biosim).
Costes tan elevados cierran la puerta a pequeñas y medianas empresas, como observó Correa.
"En el sector de los genéricos hay agentes muy diversos. Existe un gran número de compañías pequeñas en muchos países como Indonesia, Filipinas, incluyendo algunos de América Latina. Pero también grandes empresas europeas, de Canadá o de Israel".
En el mercado de los biosimilares, en cambio, la guerra de precios se libra entre grandes multinacionales farmacéuticas.
Además, desarrollar un biosimilar suele tardar entre 6 o 7 años, el doble que un genérico.

Fuente de la imagen, theasis
Campaña de desprestigio
Pero a todas estas complicaciones se suma otra que la directora de Biosim, Regina Múzquiz, califica de "infoxicación".
Los defensores de los biosimilares acusan a las grandes farmacéuticas de realizar desde hace años una "campaña de desprestigio" contra estos medicamentos.
"Algunas compañías hacen una defensa basada en desprestigiar la calidad y la seguridad de la eficacia de los biosimilares pero esto no se sostiene en absoluto", afirmó Múzquiz a BBC Mundo.
"Las autoridades que evalúan y autorizan los biosimilares son las mismas que aprueban los fármacos originales y no van a tener unos criterios con unos y otros con el resto".
"Con estas campañas sólo se desprestigian a ellos mismos", concluyó.
El lobby contra los biosimilares consiguió que estos no fueran admitidos en Estados Unidos hasta 2015, casi una década después que en Europa.
Y, aún hoy, los que han sido aprobados se pueden contar con una sola mano y se están comercializando bajo su propio riesgo, ya que se enfrentan a procesos judiciales impuestos por los fabricantes de los medicamentos originales.
En América Latina, países como México, Colombia y Argentina ya han regulado su uso.

Fuente de la imagen, vm
Pero la batalla no sólo es a nivel normativo, sino que también se da en el ámbito profesional.
"Participaciones en congresos de medicina, publicaciones de artículos... Hay una campaña para sostener que los biosimilares no son seguros", aseguró Correa.
"Se les dice a los médicos que si ya han empezado un tratamiento con un producto original, pasar al paciente a un biosimilar traería riesgos".
"Eso también crea temor a los pacientes, ya que hablamos de enfermedades que pueden ser letales".
Beneficios
Sin embargo, los biosimilares se usan en Europa desde hace 11 años y los resultados han sido positivos, según coincidieron Correa y Múzquiz.
Y si bien la caída de precios no ha sido tan espectacular como sucedió con los genéricos, ha existido.
El precio de la hormona del crecimiento en la Unión Europea disminuyó un 15% desde que apareciera un biosimilar.
Los del EPO y del G-CSF, un 27%. El de la insulina bajó, aunque sólo un 1%.
Sus costos aún son altos, pero al menos se van reduciendo.









